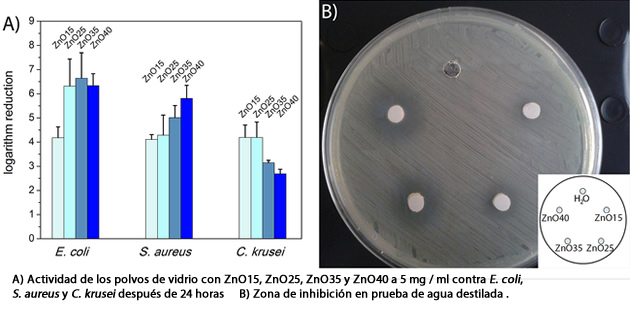
vidrios biocidas

Científicos españoles han desarrollado vidrios con un alto contenido de óxido de zinc que presentan una excelente actividad biocida contra bacterias Gram-, Gram+ y levaduras. Estos nuevos biocidas inorgánicos no causan efectos adversos en la salud o el medioambiente y no crean problemas de resistencia antimicrobiana. Su aplicación estaría en sectores como sistemas de purificación del agua, entorno médico, envases de alimentos o productos textiles.
Ante la preocupación por las enfermedades, las infecciones, la corrosión y la biocontaminación causada por microorganismos, existe una necesidad global de desarrollar nuevos agentes antimicrobianos menos contaminantes, tóxicos y nocivos para la salud que los biocidas químicos tradicionales. Asimismo, el problema de las resistencias antimicrobianas a estas sustancias es un reto cada vez mayor.
Además, los agentes antimicrobianos suelen ser compuestos orgánicos, que tienen aplicaciones limitadas debido a su baja resistencia al calor, alta descomponibilidad y corta vida. En este sentido, los biocidas inorgánicos han adquirido importancia, pero normalmente están basados en nanopartículas, que tienen efectos sobre el medioambiente y la salud humana. Por esto, el desarrollo de nuevos biocidas inorgánicos sin resistencias antimicrobianas y efectos adversos sobre los organismos vivos es esencial.
En este contexto, investigadores del Consejo Superior de Investigaciones Cientificas (CSIC) han desarrollado vidrios transparentes con un bajo punto de fusión (1250°C), con un alto contenido de óxido de zinc (15–40% porcentaje por peso), que son candidatos prometedores como agentes antimicrobianos no tóxicos.
El óxido de zinc (ZnO) presenta una elevada actividad biocida y el equipo del CSIC ha conseguido obtener vidrios con contenido de óxido de zinc de hasta el 40 % que mantienen sus propiedades biocidas sin resultar tóxicos.
Los vidrios son muy efectivos frente a bacterias Gram- (Escherichia coli), Gram + (Staphylococcus aureus) y levaduras (Candida krusei), son químicamente estables en diferentes medios y biocompatibles.
Entre sus posibles aplicaciones están, además de implantes médicos y equipos quirúrgicos, los sistemas de purificación de agua, el envasado y almacenamiento de alimentos o la producción de textiles con acción biocida.
Fuente: Leticia Esteban-Tejeda y otros: Antibacterial and Antifungal Activity of ZnO Containing Glasses. Plos One, 2015